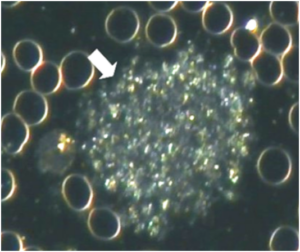

Platelets occurring in groups of various sizes, ranging from roughly half the size of a RBC to very large clusters. These are easily differentiated from WBCs as platelet aggregations lack any discernible cellular elements, such as a nucleus and distinct cell membrane.
One large group of platelets in a single sample (as pictured above) or several smaller groups of platelets is significant and indicates platelet aggregation. Platelets in normal samples do not group together and lie alone in the plasma. The size of aggregations is measured by comparing it with RBCs: an aggregation that is the same size as a RBC is a size “A” aggregation; twice the size of an RBC is size “B”; and so on.
short_description
Platelets occurring in groups of various sizes, ranging from roughly half the size of a RBC to very large clusters. These are easily differentiated from WBCs as platelet aggregations lack any discernible cellular elements, such as a nucleus and distinct cell membrane.
One large group of platelets in a single sample (as pictured above) or several smaller groups of platelets is significant and indicates platelet aggregation. Platelets in normal samples do not group together and lie alone in the plasma. The size of aggregations is measured by comparing it with RBCs: an aggregation that is the same size as a RBC is a size “A” aggregation; twice the size of an RBC is size “B”; and so on.
associated_symptoms
- Depending on the underlying cause, any combination of the following:
- Episodes of fatigue and dizziness that usually improves after eating
- Excessive thirst, hunger and frequent urination.
- Fever
- Malaise (feeling unwell)
- Fatigue
- Poor circulation
- Headaches
- Poor digestion (esp. fats and carbohydrates)
- High blood pressure
- Angina
- Blood clots with symptoms of stroke or heart attack or thrombosis is legs (DVT).
- Stress
- Asymptomatic
general_guidelines
- Follow the diet relevant to the blood type.
- Identify and avoid hidden food sensitivities.
- Increase water intake. To determine necessary daily water intake (in litres): Weight (kg) / 8) x 0.25.
- Increase intake of fibre-rich carbohydrates (those tolerated by the blood type) and raw, polyunsaturated fats.
- Raw vegetable juices (especially celery), sprouts, greens and antioxidant-rich superfoods.
- Avoid saturated fat, refined carbohydrates and food deficient in natural enzymes. Smokers: stop smoking
- Avoid alcohol, caffeine, sugar, drugs and non-essential medication.
- Smokers: stop smoking
medical_perspective
Thrombocytes play an integral role in haemostasis by forming a blood clot at the site of haemorrhage. Non-activated thrombocytes circulate freely. Once activated, they become sticky and undergo a morphological change where they assume a star-like shape and enmesh with each other and fibrin, forming a blood clot. There are a number of platelet-activating factors, including:
Thrombin an enzyme that plays many roles in the coagulation cascade, such as the conversion of soluble fibrinogen into insoluble strands of fibrin. It also promotes platelet activation directly. Collagen, which is part of the walls of blood vessels, activates thrombocytes when they come into contact with it.
Platelet activating factor (PAF), one of the mediators of inflammation produced by leukocytes involved in inflammation (eosinophils, basophils & monocytes).
- ADP (Adenosine D: Phosphate)
- Serotonin
- Adrenalin
- Vasopressin (ADH)
- Bacteria & viruses
- Antibody/antigen complex
Heart disease and strokes contribute to a large degree of mortality in the western world. Thrombocyte aggregation is known to be a major factor in these conditions and is therefore a potentially serious finding. Excessive thrombocyte aggregation can lead to various circulatory disorders, including thrombosis and blood vessel blockage resulting in tissue hypoxia or necrosis. Thrombocytes are known to be more likely to aggregate in cigarette smokers. Research has also shown that thrombocyte aggregation is increased in diabetes and dyslipidaemia. There are some conflicting studies regarding thrombocyte aggregation and oral contraceptives, but it is likely that this may be a contributing factor to thrombocyte aggregation.
pleomorphic_perspective
The work of Enderlein and other pleomorphists has shown that platelets are not fragments of the megakaryocyte as understood by conventional haematologists, but are rather thecits of the endobiont. The megakaryocyte is packed with endobionts and eventually ruptures due to the massive infestation to release the thrombocytes.
Thrombocytes are normally not pathogenic, unless they occur in large numbers or develop into groups, called thrombocyte symplasts. Thrombocyte symplastism is an agglutination of thrombocytes, colloids and wastes. This environment is an ideal medium for the upward development of the pathogenic phases of the endobiont, which can only occur when the terrain of the body allows for it. Conventional medicine agrees that activated thrombocytes and thrombocyte aggregation plays a critical role in blood coagulation. Enderlein called Mucor racemosus the congester, responsible for excessive fibrin and thrombocytes in its pathogenic phases.
implications
- Normal, disc-shaped, inactive platelets do not aggregate due to various mechanisms that cause them to repel each other.
- Once activated by damaged blood vessel walls or other activator chemicals, platelets first become sticky and adhere to damaged and irregular surfaces. They then assume a star-like shape and enmesh with each other and fibrin and release chemicals that activate other platelets and cause blood vessels to contract. This forms an important part of the mechanism of coagulation that controls bleeding.
- A significant degree of platelet aggregation indicates increased cardiovascular disease risk. This is not only because platelet aggregations are “micro-clots”, but also because platelet aggregation is connected with inflammation, endothelial dysfunction and oxidative stress, which are all involved in atherosclerosis.
- Adrenalin, related to the stress response, leads to disseminated size B-C platelet aggregations.
- Blood sugar imbalance (incl. low blood sugar, insulin resistance, diabetes).
- Intestinal dysbiosis and possible Leaky Gut Syndrome is strongly connected to platelet aggregations with “bubbles” around the edges (Thrombocyte Fermentation).
- Acidic terrain
- Excess dietary animal fats (triglycerides).
- High cholesterol (high LDL and low HDL)
- High triglycerides
- Possible bleeding
- Stress, tobacco, caffeine, carbonated soft drinks (containing caffeine) and alcohol contribute.
interventions
Any combination of the following, depending on the rest of the case:
INSULIN RESISTANCE PROTOCOL:
- InsuGen / Insulin Resistance Formula + Bio-lonic Mineral Concentrate (Neogenesis Health Products).
- Avoid all refined carbohydrates and high-glycaemic foods.
- Eat every 3 hours, low glycaemic foods only.
ADRENAL PROTOCOL:
- Adrenin + Adaptone + Bio-lonic Mineral Concentrate (Neogenesis Health Products).
- DHEA (25mg initially, gradually increasing to 100mg a day).
LIVER PROTOCOL:
- Avoid alcohol, caffeine, tobacco, saturated/animal fat, sugar, drugs and non-essential medication.
- Hepaton (Neogenesis Health Products): 30 drops tincture 3x daily. May be increased to 5ml tincture 3xdaily.
INFLAMMATION PROTOCOL:
- HumiCaps (Neogenesis Health Products): 2-4 capsules 2-4x daily.
- Curcumigen (Neogenesis Health Products): 1 capsule 1-2x daily.
- Glutathione 500 (Neogenesis Health Products): 1 capsule 1-2x daily.
- Trace minerals: Bio-lonic Mineral Concentrate (Neogenesis Health Products).
- Omega-3 supplement (1000-2000 EPA daily).
SUPPLEMENTS:
- Omega-3 supplement (1000-2000 EPA daily).
- Vitamin E: start with 400mg daily and gradually increase to 800mg daily.
- Buffered vitamin C (2500mg) and/or other antioxidants such as: Super Oxide Dismutase, proanthocyanidins, N-Acetyl Cysteine, selenium (200ug), beta carotene, zinc and glutathione.
- Vitamin B3, as non-flush Niacin (1000mg daily). Niacin helps to remove excess protein and saturated fat from the blood and stimulates hydrochloric acid production by the stomach.
- Bio-lonic Mineral Concentrate (Neogenesis Health Products).
- Chromium
- Lipotropic factors
- N-Acetyl Cysteine
- Carnitine
working_with
The first priority in clients presenting with platelet aggregation is to rule out high cholesterol / triglycerides. Also rule out a high fat diet as a cause. Blood sugar imbalance is a very common cause of platelet aggregation and can be confirmed by the client’s symptoms (fatigue, dizziness, headaches, etc aggravated by missing meals, tendency to skip meals, high sugar intake, etc). Other anomalies such as delayed clearance of chylomicrons, broken fibrin in PPP, etc will also indicate the probability of a blood sugar problem. The presence of this sign is not diagnostic of insulin resistance or diabetes, although it will be observed in those that have been diagnosed as such. When platelet aggregation is due to blood sugar imbalance, there is a problem with the body’s regulation of blood glucose levels, which may only be evident after certain types of food (i.e. a fasting blood sugar test may not detect any abnormality). This sign, like many other signs in blood analysis, appears very early when abnormalities may only be detected by ordering a GTT (glucose tolerance test) with concurrent Insulin. It may also be brought on by dietary habits such as skipping meals, irregular eating patterns and high intake of sugar and high GI/GL foods. If the sign does not improve after 30 days of nutritional treatment and dietary management further tests are necessary. Hidden viral infections (EBV, Coxsackie, etc), collagen-damaging disease or vascular conditions may be the cause. Stress and raised adrenalin levels typically causes disseminated size B-C aggregates.
further_investigations
- If platelet aggregation occurs concurrent with rouleau, acute phase protein elevation caused by inflammation or tissue necrosis or allergy can be suspected (see rouleau).
- A collagen-damaging disease is possible (ANF + RF).
- Test to rule out occult disease processes which may cause collagen damage or neoplastic changes.
- Lipogram
- Glucose (fasting) + insulin / GTT (Glucose Tolerance Test) + insulin
- Clotting Profile, D-Dimer